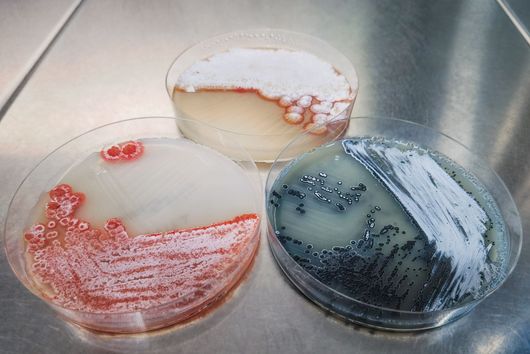
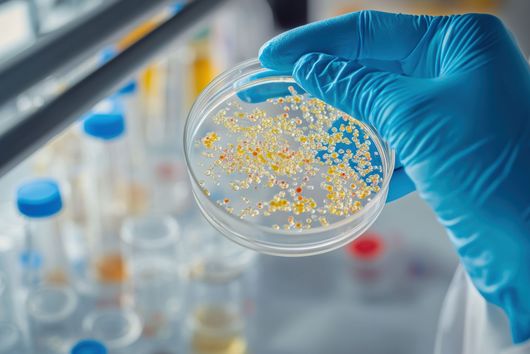
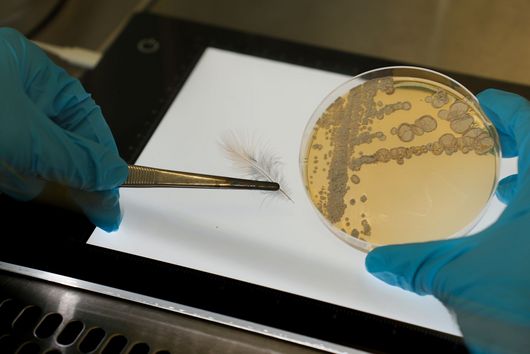
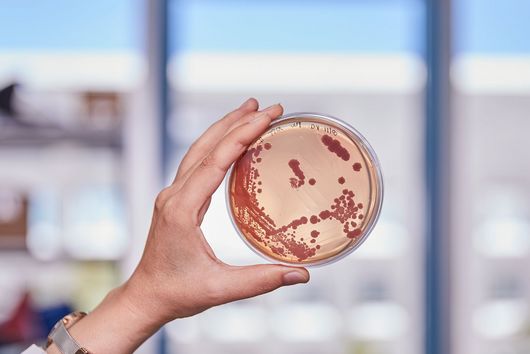

Forschung am HIPS
Die Forschung am HIPS basiert auf vier Schwerpunkten: Mikrobielle Naturstoffe, Wirkstoff-Design und Optimierung, Biologische Barrieren und Wirkstofftransport, und Wirkstoff-Bioinformatik. Enge Zusammenarbeit zwischen diesen Forschungsgebieten erlaubt es uns die Entwicklung neuer Antiinfektiva effizient voranzutreiben.
"Die Entwicklung neuartiger Antibiotika ist derzeit nur in enger Zusammenarbeit mit verschiedenen akademischen und industriellen Partnern möglich. In zahlreichen Kooperationen und öffentlich-privaten Partnerschaften wollen wir die durch Marktversagen verursachte Translationslücke überbrücken, um die Entwicklung von Antiinfektiva im Kampf gegen antimikrobielle Resistenz zu ermöglichen."
Rolf Müller, Geschäftsführender Direktor des Helmholtz-Instituts für Pharmazeutische Forschung Saarland (HIPS) und Leiter der Abteilung Mikrobielle Naturstoffe
Stellenangebote
Auf der Suche nach einem spannenden und anspruchsvollen Job? Hier geht’s zu den aktuellen Stellenangeboten am HIPS.










![[Translate to German:] Alexandra K. Kiemer, Simon Both, Martin Empting](/fileadmin/HIPS/__processed__/c/6/csm_Kiemer_Both_Empting_7700535100.jpg)

![[Translate to English:] Illustration](/fileadmin/HIPS/__processed__/b/6/csm_WebNews_DataLeakage_53fd0ef4a5.png)

![[Translate to German:] [Translate to German:]](/fileadmin/HIPS/__processed__/c/9/csm_HZI_wiss_hemmhof_mik_001_611abc3df4.jpg)




![[Translate to German:] [Translate to German:]](/fileadmin/HIPS/__processed__/1/b/csm_Andreas_Keller_2023_org_4a279f0c07.jpg)

![[Translate to German:] [Translate to German:]](/fileadmin/HIPS/__processed__/b/3/csm_AufDiePlaetze_WID-8615_4ee837e55b.jpg)

![[Translate to German:] Künstliche Intelligenz unterstützt die Entdeckung von Arzneimitteln aus Naturstoffen](/fileadmin/HIOH/__processed__/3/e/csm_AI_in_NP_Drug_Discovery_AdobeStock_09ad758135.jpg)






































![[Translate to Deutsch:] [Translate to Deutsch:]](/fileadmin/HIPS/__processed__/2/b/csm_HZI_wiss_pseudomonas_cpi_hzi_001_62730ae12d.jpg)


















